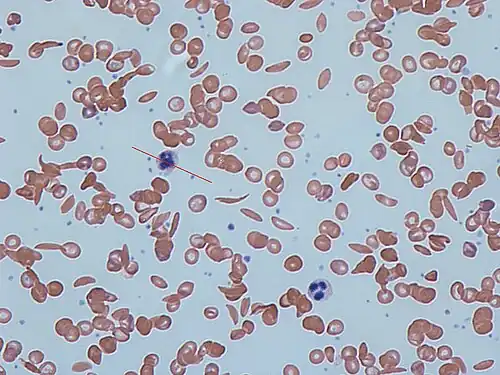

Internal Medicine/Peripheral Blood Smears
- Normal blood smear
- Iron-deficiency Anemia
.jpg)
- Polychromatophilia
- Macrocytosis

- Hypersegmented neutrophils

- Spherocytosis
- Rouleaux formation

- Red cell agglutination

- Sickle cells
- Target cells

- Elliptocytosis

- Stomatocytosis

- Acanthocytosis

- Howell-Jolly bodies

- Teardrop cells

- Nucleated red blood cells
_in_a_Wright's_stained_peripheral_blood_smear_(PBS)_microscopy_of_an_aplastic_anemia_patient.jpg)
- Lead poisoning

- Pelger-Hüet anomaly